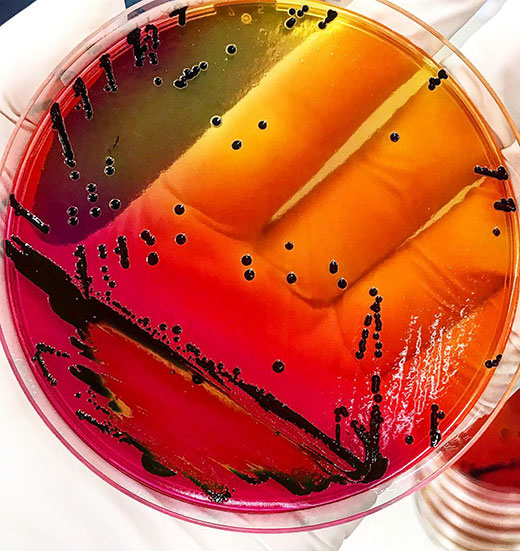

Salmonella bacteria (pictured) is found in approximately 18% of ground turkey samples, according to a 2021 report from the U.S. Department of Agriculture. (Photo courtesy of Jessie Vipham, K-State Department of Animal Sciences and Industry)
$589K grant aims to set up pre-harvest control points to reduce risk of contamination.
Researchers from Kansas State University and the USDA’s Agricultural Research Service have teamed with scientists from one of the world’s largest food companies to conduct a study they hope can help decrease the incidence of Salmonella in ground turkey.
Jessie Vipham, an assistant professor in K-State’s Department of Animal Sciences and Industry, was recently awarded a grant for $589,800 from the USDA’s National Institute of Food and Agriculture to explore ways to predict Salmonella contamination in turkey flocks before they are harvested.
Last year, the USDA reported that while Salmonella is rarely detected in whole turkeys, inspectors found it in 18% of ground turkey samples taken in 2020.
“Our goal is to identify an effective pre-harvest, pre-grind sample to predict Salmonella contamination in turkey flocks destined for ground turkey,” Vipham said.
Vipham has formed a partnership with Cargill and senior research scientist Anna Carlson to conduct the on-farm tests.
“Turkey producers will be able to use this sampling strategy to create diversion programs for turkey flocks to be harvested at specific times – such as the last part of the day – or for turkey parts to be used in specific programs,” Carlson said. “That will help to reduce the risk of cross-contamination within the facility.”
Currently, how, where and at what amount Salmonella exists in turkey operations is not fully known. “Our approach,” Vipham said, “will help unlock some of the mystery surrounding Salmonella contamination in ground turkey, and will aid in identifying targeted control points, particularly at pre-harvest.”
The researchers’ work begins in May and will continue for three years. They hope it will build on knowledge of the foodborne pathogen in turkey production, and of pre-harvest samples that accurately predict its presence in the ground product.
“Although our collaboration is with Cargill, this project was designed with the entirety of the turkey industry in mind,” Vipham said. “We have strong potential to improve pre-harvest and post-harvest practices, but we also believe this is the first study that will identify turkey risk factors for Salmonella from pre-harvest and post-harvest samples.”
In addition to Cargill, the project is backed by USDA’s Agricultural Research Service, and other faculty from K-State’s Department of Animal Sciences and Industry, including Travis O’Quinn, Valentina Trinetta and Sara Gragg, a group that “really helped in designing a project that is targeting a question that has strong industry and regulatory interest,” according to Vipham.







